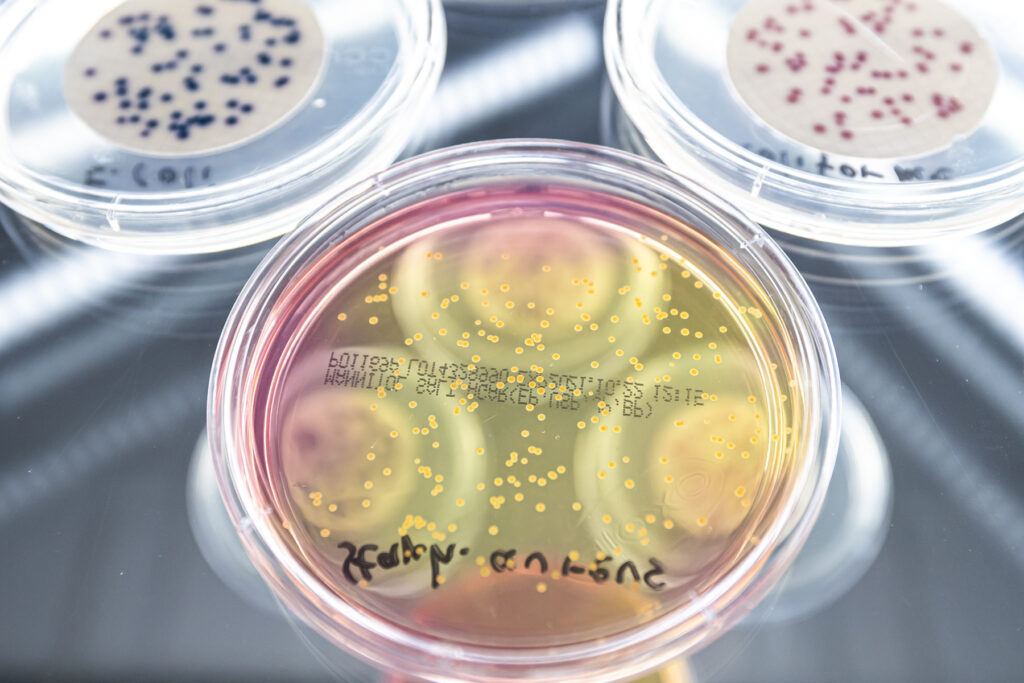

Mikrobiologische Material- und Hygieneprüfungen
Startseite » Leistungen » Mikrobiologische Material- und Hygieneprüfungen
Abteilungsleiterin
Paula Mühlnickel, M. Sc.
Sekretariat
Teamassistenz
Prüfung für den Trinkwasserkontakt
Die Qualität von Wasser für den menschlichen Gebrauch wird in Europa
über die Richtlinie EU 2020/2184 geregelt, auf nationaler Ebene in Deutschland
über die Trinkwasserverordnung (TrinkwV). Darin werden nicht nur Anforderungen
an das Trinkwasser selbst, sondern auch an die Werkstoffe und Materialien
gestellt, die bei der Gewinnung, Weiterleitung und Speicherung mit Trinkwasser
in Kontakt kommen.
§ 14 TrinkwV regelt dies konkret und fordert, dass die verwendeten Materialien und Produkte:
- die menschliche Gesundheit nicht beeinträchtigen
- den Geruch / Geschmack des Trinkwassers nicht nachteilig verändern
- die Vermehrung von Mikroorganismen nicht fördern
- möglichst keine Stoffe ins Trinkwasser abgeben.
Die Überprüfung, dass ein Produkt diesen Anforderungen entspricht erfolgt gemäß den Vorgaben der Bewertungsgrundlagen und Leitlinien des Umweltbundesamtes sowie entsprechender DVGW-Arbeitsblätter. Dabei werden sowohl
- die Prüfung hinsichtlich der Förderung des mikrobiellen Bewuchses an den Materialien und Produkten gemäß DVGW Arbeitsblatt W 270 oder DIN EN 16421 als auch
- Migrationsprüfungen mit anschließender Untersuchung der festgelegten Parameter in den generierten Kontaktwässern durchgeführt.
Für weitere Informationen zu den Migrationsprüfungen klicken Sie hier.
Prüflabor für Zertifizierungsstellen
Das Hygiene-Institut des Ruhrgebiets ist ein anerkanntes und nach DIN EN ISO 17025:2018 akkreditiertes Labor für die benötigten trinkwasserhygienischen Prüfungen. Damit wird uns die Kompetenz zur Prüfung von Materialien und Produkten der Wasserversorgung bezüglich deren hygienischer Eignung bestätigt. Die auf Basis der Bewertungsgrundlagen, Leitlinien und DVGW Arbeitsblätter erstellten Prüfberichte und Prüfzeugnisse werden von Zertifizierungsstellen wie der HyCert.
Hier finden Sie weitere Informationen zum Querschnittsthema Zertifizierung und unserer Zertifizierungsstelle HyCert.
Unser Leistungsspektrum
Wir führen trinkwasserhygienische Eignungsprüfungen an nichtmetallischen Werkstoffen kompetent für Sie durch. Unser Leistungsspektrum umfasst die Prüfung von organischen Werkstoffen bzw. Werkstoffen mit organischen Bestandteilen. Dazu zählen Kunststoffe aller Art, Elastomere, Silikone, Beschichtungen und zementgebundene Werkstoffe.
Materialien für den Einsatz im Trinkwasserbereich
- Prüfung nach DIN EN 16421 (KTW-BWGL)
- Prüfung nach DVGW Arbeitsblatt W 270
Daneben bieten wir in unserer Abteilung auch weitere mikrobiologische Materialprüfungen und Hygieneprüfungen sowie einen Beratungs- und Fortbildungsservice an. Die nachfolgend aufgeführten Normen und technischen Regelwerke bilden unsere Prüfgrundlagen.
Mikrobiologische Materialprüfungen
Antimikrobielle Ausrüstung / Verstoffwechselbarkeit
- Prüfung nach ISO 22196 / JIS 2801 / ASTM 2180
- Prüfung nach DIN EN ISO 846
Prüfung chemischer Desinfektionsverfahren
- Prüfung nach DIN EN (Quantitative Suspensionsverusche)
Mikrobiologische Untersuchung von Rohstoffen, Zwischen- und Endprodukten
- Prüfung auf mikrobiologische Qualität (Ph.Eur. / USP)
- Prüfung auf ausreichende Konservierung
Weitere mikrobiologische Untersuchungen
- Prüfung von Reinigungs- und Desinfektionsmaßnahmen
- Prüfung von Behältnissen aus Hüttenglas
- Prüfung von Haushaltswasserfiltersystemen (DIN EN 17093, DVGW Arbeitsblatt W 516)
- Untersuchung von Umweltproben (z.B. Klärschlamm, Kompost, Spielsand)
- Aufbau produktspezifischer Prüfanlagen (z.B. für endständige Wasserfilter)
Sie haben spezielle Fragestellungen? Sprechen Sie uns an!